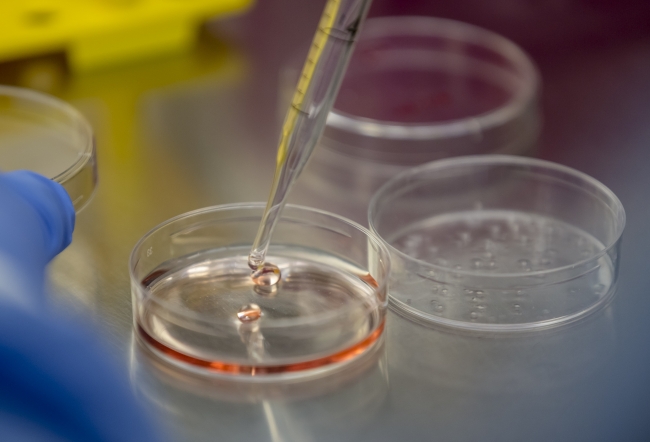

Yumurta azlığı nedeniyle gebe kalamayan anne adaylarının kök hücre yöntemiyle tedavisi için bilimsel çalışmalar yapılıyor.
19 Mayıs Üniversitesi Kök Hücre Uygulama ve Araştırma Merkezi'nde araştırmacılar bu yöntem üzerinde çalışıyor.
Merkezde, hastaların farklı dokularından alınan kök hücreler izole ediliyor.
Kısırlık tedavisinde kök hücre
Samsun 19 Mayıs Üniversitesi'nde çalışan Doktor Melek Yüce, "Kök hücreler şu anlamda önemli belirli hastalıkların tedavisinde yönelik hala önemli bir umut ışığı olarak devam ediyor" açıklamasını yaptı.
Yumurta azlığı yaşayan kadınların anne olma ihtimali çok düşük. Çalışmalarla yumurta rezervlerinin artırılması amaçlanıyor.
Düşük yumurta rezervlerinin kök hücre ile artırılması hedefleniyor
19 Mayıs Üniversitesi Tıp Fakültesi Öğretim Üyesi Dr. Ayşe Zehra Özdemir, "Çaresiz hasta grubumuz var. Özellikle yumurtalıklarında erken yaşlanma olan ya da bizim yumurtalık rezervi düşük dediğimiz hastalar bizi oldukça zorluyor. Bizim amacımız bu hücreleri yerine koyabilecek veya bu hücrelerin daha yavaş bir şekilde yaşlanmasını sağlayacak kök hücre desteklerini bulmak" dedi.
Araştırmalar, çocuk hasreti çeken birçok aileye kök hücre yönteminin çare olması umuduyla yürütülüyor.